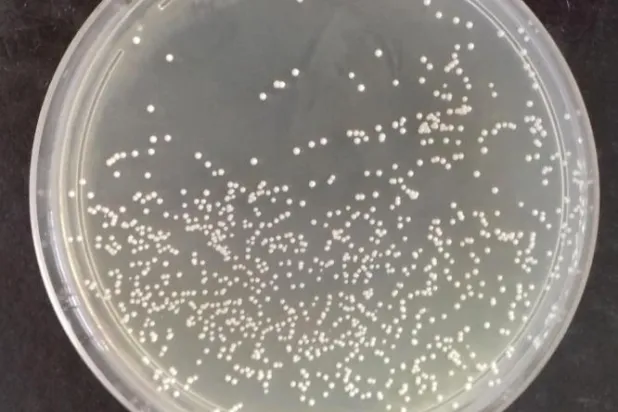
الخميرة المستخدمة في إنتاج الخبز ومنتجات أخرى (الفريق البحثي)

science
science
من الطبيعي أن يشعر الجميع بالقلق في أوقات مختلفة من حياتهم، مثل أن تكون قلقاً بشأن ترك انطباع أول جيد لدى عائلة شريك حياتك الجديد، أو تكون قلقاً في الأيام التي تسبق اجتماعاً مهماً، بشأن ما سترتديه. والقلق عندما يكون في الحدود المعقولة تكون له فوائده؛ فوفقاً للتحالف الوطني للأمراض العقلية بأميركا، فإن المستويات المعقولة منه تبقيك متيقظاً عندما تكون خلف عجلة القيادة أثناء عاصفة ثلجية، على سبيل المثال، أو تساعدك على الاستعداد بشكل أفضل لعرض عمل. ولكن المشكلة تظهر عندما يتحول من الشكل الصحي إلى المرضي، لدرجة أنه يعد اضطراباً في الصحة العقلية، وعندما يحدث ذلك، يمكن أن تكون له آثار عاطفية وجسدية وعق
تُعد فوائد النوم الجيد معروفةً للكثير من الأشخاص حول العالم، حيث إن النوم ليلاً والاسترخاء يمكن أن يحسنا يومك وصحتك. لكن يقترح الباحثون الآن أن النوم الجيد، بعيداً عن كونه ممتعاً، قد يضيف سنوات إلى حياة الناس، وفقاً لصحيفة «الغارديان». توصلت دراسة جديدة إلى أن الرجال الذين ينامون بشكل جيد يمكن أن يعيشوا ما يقرب من خمس سنوات أطول من أولئك الذين لا يفعلون ذلك، في حين أن النساء يمكن أن يستفدن بعامين، ويمكن للأشخاص أيضاً الاستمتاع بصحة أفضل خلال حياتهم. وجد الباحثون أن الشباب الذين لديهم عادات نوم أفضل كانوا أقل عرضة للوفاة مبكراً.
أظهرت دراسة برازيلية أن تناول جرعة يومية من سلالة «خميرة البيرة» المستخدمة في إنتاج الخبز، يمكن أن يكون بمثابة وقاية من الربو.
في روايته الكلاسيكية «جيرني تو ذا سنتر أوف ذي إيرث (رحلة إلى مركز الأرض)» الصادرة عام 1864، يحكي جول فيرن قصة مغامرين دخلوا باطن الأرض عبر بركان في أيسلندا ليكتشفوا عالماً شاسعاً تسكنه مخلوقات من قبل التاريخ ويستكشفوا البنية الداخلية للكوكب. لكن مركز الأرض الحقيقي لا يمتّ بصلة إلى هذا التصور الخيالي، بل إنه أكثر إثارة نوعاً ما. فوفقاً لوكالة «رويترز» للأنباء، أكدت دراسة مكثفة عن أعماق كوكب الأرض، استناداً إلى حركة الموجات الزلزالية الناشئة عن الزلازل الضخمة، وجود بنية مميزة واضحة المعالم داخل اللب الداخلي لكوكب الأرض.
قد تكون بعض الظواهر الفيزيائية اليومية جزءاً مفقوداً في جهود العلماء للتنبؤ بأقوى الزلازل في العالم، ومنها ما يعرف بـ«ظاهرة الاحتكاك». وفي دراسة نُشرت في العدد الأخير من مجلة «ساينس»، اكتشف باحثون في جامعة تكساس الأميركية، أن هذه الظواهر يمكن أن تكون «مفتاحاً لفهم متى وكيف تتحرك الفوالق بعنف»، لا سيما أنها تحكم مدى سرعة ارتباط أسطح الفوالق ببعضها بعد الزلزال. وهذا وحده لن يسمح للعلماء بالتنبؤ بـ«متى سيضرب الزلزال التالي»، لأن القوى الكامنة وراء الزلازل الكبيرة «معقدة للغاية»، لكنه يمنح الباحثين «طريقة جديدة للتحقيق في أسباب واحتمالية حدوث زلزال كبير ومدمر». ويقول المؤلف المشارك في الدراسة ديمي
بينما تسبب صدع «شرق الأناضول» في الزلزالين المدمرين اللذين شهدتهما تركيا مؤخراً، فإن صدعاً آخر يسمى «شمال الأناضول»، كان آخر نشاط مدمر له في عام 1999، ويخشى الخبراء أن أي نشاط زلزالي ناتج عن هذا الصدع، سيكون تأثيره مدمراً على مدينة إسطنبول، القريبة منه. وتقع تركيا على هذين الصدعين الرئيسيين، ويتوقع باحثو الزلازل أن زلزالاً بقوة 7 درجات أو أقوى من المرجح جداً أن يضرب إسطنبول، القريبة من صدع «شمال الأناضول»، خلال الـ70 عاماً المقبلة. وتتعرض الصفيحة الأناضولية الشمالية والشرقية لضغوط تكتونية من قبل الصفيحتين العربية والأوراسية، إذ يجري دفع الصفيحة الأناضولية باتجاه الغرب، وهذه الحركة يمكن أن تتسب
يعود الفضل إلى إسحاق نيوتن في صياغة نظرية الجاذبية لأول مرة في النصف الأخير من القرن السابع عشر (مستوحاة على ما يبدو من سقوط تفاحة من شجرة). لكن الجوانب الأساسية لقانون الجاذبية تم التعرف عليها أيضًا من قبل ليوناردو دافنشي قبل أكثر من مائة عام، وفق ما توضح دراسة جديدة منشورة في «ليوناردو». فقد حللت الدراسة الرسوم البيانية في دفاتر ليوناردو الرقمية، بما في ذلك الرسومات التخطيطية للمثلثات التي توضح العلاقة بين الحركة الطبيعية والحركة الموجهة ومعادلة الحركة؛ وهو إدراك أن الجاذبية نوع من التسارع. ففي حالة ليوناردو، كان هذا ينطوي على التفكير في الرمل المتدفق من الجرة.
بينما لم يصدر عن الولايات المتحدة الأميركية أي تفاصيل تتعلق بثلاثة أجسام طائرة «مجهولة»، تم الإعلان عن إسقاطها أيام 10 و11 و12 فبراير (شباط) الجاري، استبق خبراء التحقيقات التي تجريها واشنطن، ورجحوا أن هذه الأجسام لا تخرج عن كونها «مناطيد لمراقبة الطقس». وذهب الخبراء إلى أنه «منذ أسقطت الولايات المتحدة الأميركية في 4 فبراير الجاري، المنطاد الصيني، أصيبت على ما يبدو بـ(فوبيا)، ما جعلها تتعامل مع كل جسم طائر باعتباره وسيلة للتجسس، إلى أن تثبت الفحوصات التي سيتم إجراؤها لاحقاً العكس». ويملك الخبراء من الدلائل ما يجعلهم يبرئون الأجسام الثلاثة من أي أغراض غير علمية، من بينها الارتفاع؛ حيث كانت على ا
قال فلاديمير كوزيفنيكوف، كبير مصممي محطة الخدمة المدارية الروسية المخطط لها، في مقابلة نشرت اليوم (الاثنين)، إنه على الرغم من المشكلات المستمرة في محطة الفضاء الدولية، لا تزال روسيا تتمسك بخطط بناء منشآتها الخاصة. وقال كوزيفنيكوف لوكالة الأنباء الحكومية «تاس»، إنه سيتم الانتهاء من تصميم المحطة المدارية بحلول نهاية عام 2023. وفي وقت سابق، ظهرت مشكلات مع مركبة شحن فضائية أخرى تابعة لوكالة الفضاء الروسية «روسكوزموس»، المملوكة للدولة والمسؤولة عن الرحلات وبرامج رواد وأبحاث الفضاء. وحدث تسرب بمركبة الشحن الفضائية «بروغرس إم إس 21»، التي تم وصلها بمحطة الفضاء الدولية منذ أكتوبر (تشرين الأول)؛ حيث يو
تحتاج الابتكارات الطبية عادةً إلى مرور 17 عاماً من نشأتها حتّى تسجيل أوّل فائدة لها لتصبح موجودة حقاً. ولكن في بعض الأحيان، تكون الفكرة قويّة وعميقة جداً بحيث نشعر بتأثيراتها بسرعة أكبر. تنطبق هذه الحالة على تقنية «كريسبر» للتعديل الجيني التي تحتفل بعيدها العاشر هذا الشهر.
هل يمكن أن يصبح غسل ملابسنا بالمنظفات شيئاً من الماضي؟
اكتشف باحثو جامعة الملك عبد الله للعلوم والتقنية (كاوست) أن البكتيريا الصحراوية يمكن أن تُمثل مُفتاح النجاة لتحسين صحة كلٍّ من النبات والإنسان، حيث تمكن الباحثون على مدار السنوات الثماني الماضية، من معرفة كيف تتفاعل الميكروبات مع النباتات الصحراوية بشكل ساعدها على البقاء حتى في الظروف الأكثر تطرفاً على الأرض، مثل الجفاف، أو فرط الملوحة، أو السخونة، وعملوا على استغلال الدور النافع لهذه الميكروبات لصالح نباتات المحاصيل، لتزدهر الزراعة في المناطق القاحلة، أو في ظل الظروف البيئية القاسية. ميكروبات صحراوية جمع البروفيسور هريبرت هيرت، أستاذ علوم النبات في «كاوست»، مع فريقه عدة آلاف من سلالات هذه الم
اكتشف فريق دولي مكون من 59 عالماً، نظاماً حلقياً يشبه حلقات كوكب زحل، بأحد الكواكب القزمة على حافة النظام الشمسي.
أدخل نشطاء بمواقع التواصل الاجتماعي مجدداً، مشاهد من مدينة الإسكندرية المصرية في علاقة مباشرة مع الزلزال الذي ضرب تركيا وسوريا، الاثنين الماضي، كان آخرها تغيُّر لون البحر إلى الأسود. وانتشرت صورٌ لبحر الإسكندرية وقد أصبحت مياهه تميل إلى اللون الأسود، وهو مشهد مألوف بالنسبة لسكان الإسكندرية، عند حدوث النوّات.
اقترب زلزال تركيا من رقم 8 درجات على مقياس ريختر، ليكون قريباً من رقم 9.5 درجة، المسجل كأقوى زلزال، وهو الذي شهدته تشيلي قبل 63 عاماً. في 22 مايو (أيار) 1960، ضرب زلزال مدمر جنوب تشيلي، حيث اهتزت الأرض بعنف لدرجة أن الناس لم يتمكنوا من الوقوف على أقدامهم، وكان الزلزال الذي سُمي «زلزال فالديفيا»، نسبة إلى أقرب مدينة إلى مركزه، بقوة 9.5 على مقياس ريختر، وهو أكبر زلزال تم تسجيله على الإطلاق وفق تقرير هيئة المسح الجيولوجي الأميركية، لكن هل يمكن للزلازل أن تتعدى هذا المعدل؟ يقول علماء الجيولوجيا، نظرياً لا يوجد ما يمنع. ومع ذلك، فإن احتمالات ذلك منخفضة.
أعلنت شركة بريطانية عن ابتكار أول مغناطيس «فائق» في العالم يمكن استخدامه في مجال توليد الطاقة من الاندماج النووي. ووفقاً لصحيفة «الإندبندنت» البريطانية؛ فقد قالت شركة «توكاماك إنيرجي» إن مغناطيس «Demo4» لديه مجال مغناطيسي أقوى بنحو مليون مرة من المجال المغناطيسي للأرض، مما يجعله قادراً على حصر البلازما شديدة الحرارة التي يجري إنشاؤها أثناء عملية الاندماج والتحكم فيها. وجرى الترحيب بالاندماج النووي بوصفه «الكأس المقدسة» للطاقة النظيفة، حيث يعمل العلماء على هذه التكنولوجيا منذ الخمسينات من القرن الماضي. ولإنتاج الطاقة، تستخدم محطات الطاقة النووية حول العالم حالياً «الانشطار» الذي يقوم على شطر نو
عادة ما تلقى فكرة «إعادة استخدام مياه الصرف الصحي المعالجة» نفوراً من معظم الناس، لكن في ظل ندرة المياه التي تُشكِّل تهديداً عالميّاً لا يُستهان به، والتوقعات بأن تزداد هذه الأزمة تفاقماً من جرّاء التغير المناخي، يمكن لهذه المياه أن تكون أحد الحلول الواقعية لمواجهة هذه الأزمة، حسب الدكتورة بيينغ هونغ، اختصاصية الميكروبيولوجي، والأستاذة المشاركة بقسم العلوم والهندسة والبيئية في «كاوست». معالجة مياه الصرف توضح د.
عندما تتفكّك النفايات البلاستيكية إلى أجزاء صغيرة جداً - بعرضٍ أقلّ من واحد ميكرومتر؛ أي ألف مرّة أرقّ من الشعرة البشرية - يصبح من المستحيل رصدها في معامل معالجة المياه. ولكنّ باحثين نجحوا أخيراً في تطوير مادّة جديدة قادرة على التقاط هذه الأجزاء والتخلّص منها قبل وصولها إلى مياه الأنهار والمحيطات ودخولها في السلسلة الغذائية. تأتي هذه المادّة، التي صُمّمت على شكل مسحوق مصنوع من نفايات معادة التدوير، بهيكل نانوي الحجم مصمّم لالتقاط البلاستيك غير المرئي.
من المعتاد أن يجد المهتمون بمتابعة الأبحاث العلمية قائمة بأسماء الباحثين المشاركين في الأبحاث، ووسائل تواصل خاصة بهم، لكن كانت المفاجأة التي أحدثت دوياً في الأوساط البحثية، أن إحدى الباحثات كتبت مقالة افتتاحية في إحدى الدوريات العلمية المتخصصة، وكان الباحث المشارك معها، هو برنامج الذكاء الصناعي «تشات جي بي تي». نصوص ذكية ويُنشئ «تشات جي بي تي» chatGPT نصاً واقعياً وذكياً استجابة لطلب المستخدم، وذلك عن طريق الشبكات العصبية التي تتعلم أداء مهمة عن طريق هضم كميات هائلة من النصوص الموجودة التي تم إنشاؤها بواسطة الإنسان، وأصدرت شركة البرمجيات «أوبن إيه آي»، ومقرها سان فرنسيسكو بأميركا، الأداة في 30
تقلع سيّارة كهربائية جديدة مصممة للطيران والسير على الطرقات، مثل الطائرات ذات الإقلاع والهبوط العمودي، ومن ثمّ تسير على الطريق السريع بسرعة 112 كلم في الساعة. وتضمّ طائرة «أسكا آس 5» Aska AS5عجلات جعلت منها علامة فارقة عن سائر الطائرات الكهربائية التي تقلع وتحطّ. استعرضت شركة «أسكا» من كاليفورنيا «سيّارتها الطائرة» بمجسّم كامل لتصميمها الداخلي في معرض الإلكترونيات الاستهلاكية الذي جرى أخيراً في لاس فيغاس.
اكتشف علماء وهم يدققون بالمياه المجمدة العادية في وعاء من الكرات الفولاذية شديدة البرودة، شكلاً من الجليد لم يكن معروفًا من قبل، أقرب إلى الماء السائل من أي جليد آخر حتى الآن. وهذا الجليد غير متبلور شكل غير موجود في الطبيعة على الأرض؛ ذلك لأن ذراته ليست مرتبة بنمط بلوري أنيق متكرر، ولكنها مختلطة مع كل الأنواع؛ وهي ذرات ذرية شاملة. حيث ان الجليد غير المتبلور الناتج عن تجارب الفريق (وهي عملية تسمى الطحن الكروي) يختلف عن أي جليد غير متبلور شوهد على الإطلاق. وعادةً ما يكون الجليد غير المتبلور منخفض الكثافة (حوالى 0.94 غرام لكل سنتيمتر مكعب) أو كثافة عالية تبدأ من 1.13 غرام لكل سنتيمتر مكعب.
أكدت دراسة جديدة أن الأشخاص الذين يتشاركون المعتقدات السياسية نفسها لديهم «بصمات عصبية» متماثلة في المخ، وبالتالي فإن إجراء مسح للدماغ قد يكشف الميول السياسية للأشخاص. وبحسب صحيفة «التلغراف» البريطانية، فقد أجريت الدراسة بواسطة فريق من الباحثين التابعين لجامعة براون بالولايات المتحدة، وشملت عدداً من الأشخاص الذين يعرّفون أنفسهم بأنهم ليبراليون سياسياً أو محافظون سياسياً. وقام الفريق بقياس نشاط الدماغ لدى المشاركين جميعاً أثناء مشاهدتهم مقاطع فيديو عن قضايا اجتماعية حساسة مثل الإجهاض والهجرة. ووجد الباحثون أن أدمغة المشاركين الذين يتشاركون الميول والمعتقدات السياسية ذاتها كانت تتفاعل مع الفيديو
نجح علماء صينيون في استنساخ 3 «أبقار خارقة» يمكنها إنتاج كمية كبيرة جداً من الحليب، حسبما ذكرت وسائل الإعلام الحكومية. وذكرت صحيفة «نينغشيا» اليومية التي تديرها الدولة أن الأبقار الثلاث تم استنساخها على يد علماء تابعين لجامعة «نورث ويسترن» للعلوم والتكنولوجيا، وذلك باستخدام خلايا أذن أبقار عالية الإنتاجية من سلالة هولشتاين فريزيان، التي تعيش في هولندا. وتتميز أبقار هولشتاين فريزيان بقدرتها على إنتاج 18 طناً من الحليب سنوياً أو نحو 100 طن من الحليب خلال حياتها، وهو ما يقرب من 1.7 ضعف كمية الحليب التي ينتجها البقر العادي في المتوسط، وفقا لما ذكرته شبكة «سي إن إن» الأميركية. وقال العلماء إن هذه ا
«بيكولينات الكروم» هو مكمل يأخذه العديد من الناس؛ حيث يتم الترويج له على أنه مفيد لمرضى السكري، غير أن هذه الفائدة لم يتم حسمها، ويوجد جدل علمي بشأنها؛ حيث تنفي دراسة علمية نشرتها مجلة «كلينكال نيوتريشن ريسيرش» وجود أي فوائد له. وبينما ذهبت دراسة «كلينكال نيوتريشن ريسيرش» المنشورة في أبريل (نيسان) 2020 إلى أن الأشخاص المصابين بداء السكري من النوع الثاني، لم يكن لمكملات الكروم أي تأثير مفيد لهم، سواء على مستوى الوزن أو مستويات السكر في الدم، قالت دراسة «جورنال أوف تريس إليمنتس إن ميدسين آند بيولوجي»، المنشورة في مارس (آذار) 2018، إن «بيكولينات الكروم» قد تقلل من خطر مقاومة الأنسولين، وبالتالي ق
لم تشترك بعد
انشئ حساباً خاصاً بك لتحصل على أخبار مخصصة لك ولتتمتع بخاصية حفظ المقالات وتتلقى نشراتنا البريدية المتنوعة